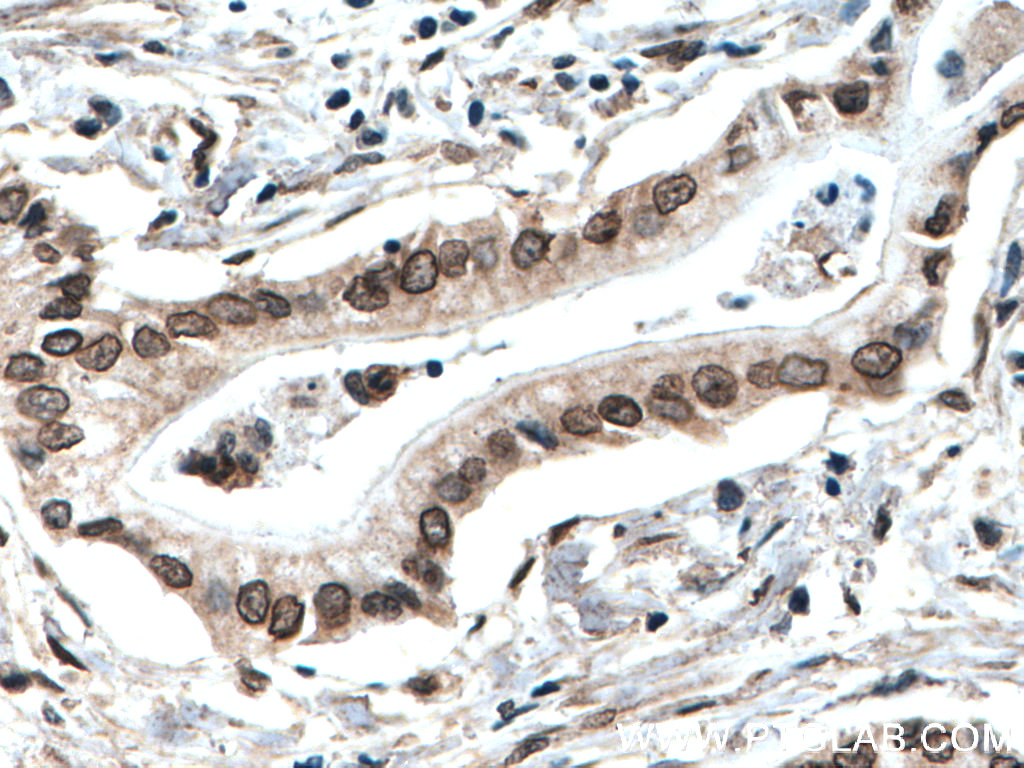

验证数据展示
经过测试的应用
| Positive WB detected in | U-251 cells, Raji cells, A549 cells, SH-SY5Y cells, MDA-MB-231 cells, PC-3 cells |
| Positive IHC detected in | human liver cancer tissue, human breast cancer tissue, human pancreas cancer tissue Note: suggested antigen retrieval with TE buffer pH 9.0; (*) Alternatively, antigen retrieval may be performed with citrate buffer pH 6.0 |
| Positive IF/ICC detected in | L02 cells |
推荐稀释比
| 应用 | 推荐稀释比 |
|---|---|
| Western Blot (WB) | WB : 1:1000-1:4000 |
| Immunohistochemistry (IHC) | IHC : 1:50-1:500 |
| Immunofluorescence (IF)/ICC | IF/ICC : 1:300-1:1200 |
| It is recommended that this reagent should be titrated in each testing system to obtain optimal results. | |
| Sample-dependent, Check data in validation data gallery. | |
产品信息
25465-1-AP targets TWIST1-specific in WB, IHC, IF/ICC, CoIP, ChIP, ELISA applications and shows reactivity with human, mouse samples.
| 经测试应用 | WB, IHC, IF/ICC, ELISA Application Description |
| 文献引用应用 | WB, IHC, IF, CoIP, ChIP |
| 经测试反应性 | human, mouse |
| 文献引用反应性 | human, mouse, rat, zebrafish |
| 免疫原 |
CatNo: Ag21924 Product name: Recombinant human TWIST1 protein Source: e coli.-derived, PET28a Tag: 6*His Domain: 12-72 aa of BC036704 Sequence: PADDSLSNSEEEPDRQQPPSGKRGGRKRRSSRRSAGGGAGPGGAAGGGVGGGDEPGSPAQG 种属同源性预测 |
| 宿主/亚型 | Rabbit / IgG |
| 抗体类别 | Polyclonal |
| 产品类型 | Antibody |
| 全称 | twist homolog 1 (Drosophila) |
| 别名 | TWIST1, ACS3, bHLHa38, BPES2, BPES3 |
| 计算分子量 | 202 aa, 21 kDa |
| 观测分子量 | 25-30 kDa |
| GenBank蛋白编号 | BC036704 |
| 基因名称 | TWIST1 |
| Gene ID (NCBI) | 7291 |
| RRID | AB_2880093 |
| 偶联类型 | Unconjugated |
| 形式 | Liquid |
| 纯化方式 | Antigen affinity purification |
| UNIPROT ID | Q15672 |
| 储存缓冲液 | PBS with 0.02% sodium azide and 50% glycerol, pH 7.3. |
| 储存条件 | Store at -20°C. Stable for one year after shipment. Aliquoting is unnecessary for -20oC storage. |
背景介绍
Twist-related protein 1 (TWIST1), also named as BHLHA38, is 202 amino acid protein, which contains one bHLH domain. TWIST1 localizes in the nucleus and acts as a transcriptional regulator. TWIST1 inhibits monogenesis by sequestrating E proteins and inhibits tans-activation by MEF2. TWIST1 is expressed in subset of mesodermal cells. The antibody reacts specifically with Twist1 protein. The calculated molecular weight of TWIST1 is 21 kDa, but the observed molecular weight is about 30 kDa due to the post-translational modification(PMID: 30733340).
实验方案
| Product Specific Protocols | |
|---|---|
| IF protocol for TWIST1-specific antibody 25465-1-AP | Download protocol |
| IHC protocol for TWIST1-specific antibody 25465-1-AP | Download protocol |
| WB protocol for TWIST1-specific antibody 25465-1-AP | Download protocol |
| Standard Protocols | |
|---|---|
| Click here to view our Standard Protocols |
发表文章
| Species | Application | Title |
|---|---|---|
Sci Adv Phospholipid remodeling is critical for stem cell pluripotency by facilitating mesenchymal-to-epithelial transition. | ||
Theranostics Vitamin D binding protein (VDBP) hijacks twist1 to inhibit vasculogenic mimicry in hepatocellular carcinoma | ||
J Exp Clin Cancer Res ACTN1 promotes HNSCC tumorigenesis and cisplatin resistance by enhancing MYH9-dependent degradation of GSK-3β and integrin β1-mediated phosphorylation of FAK | ||
Int J Biol Macromol Fucoidan/chitosan layered PLGA nanoparticles with melatonin loading for inducing intestinal absorption and addressing triple-negative breast cancer progression | ||
Int J Nanomedicine Combined miR-181a-5p and Ag Nanoparticles are Effective Against Oral Cancer in a Mouse Model | ||
Clin Transl Med FABP4 deactivates NF-κB-IL1α pathway by ubiquitinating ATPB in tumor-associated macrophages and promotes neuroblastoma progression. |